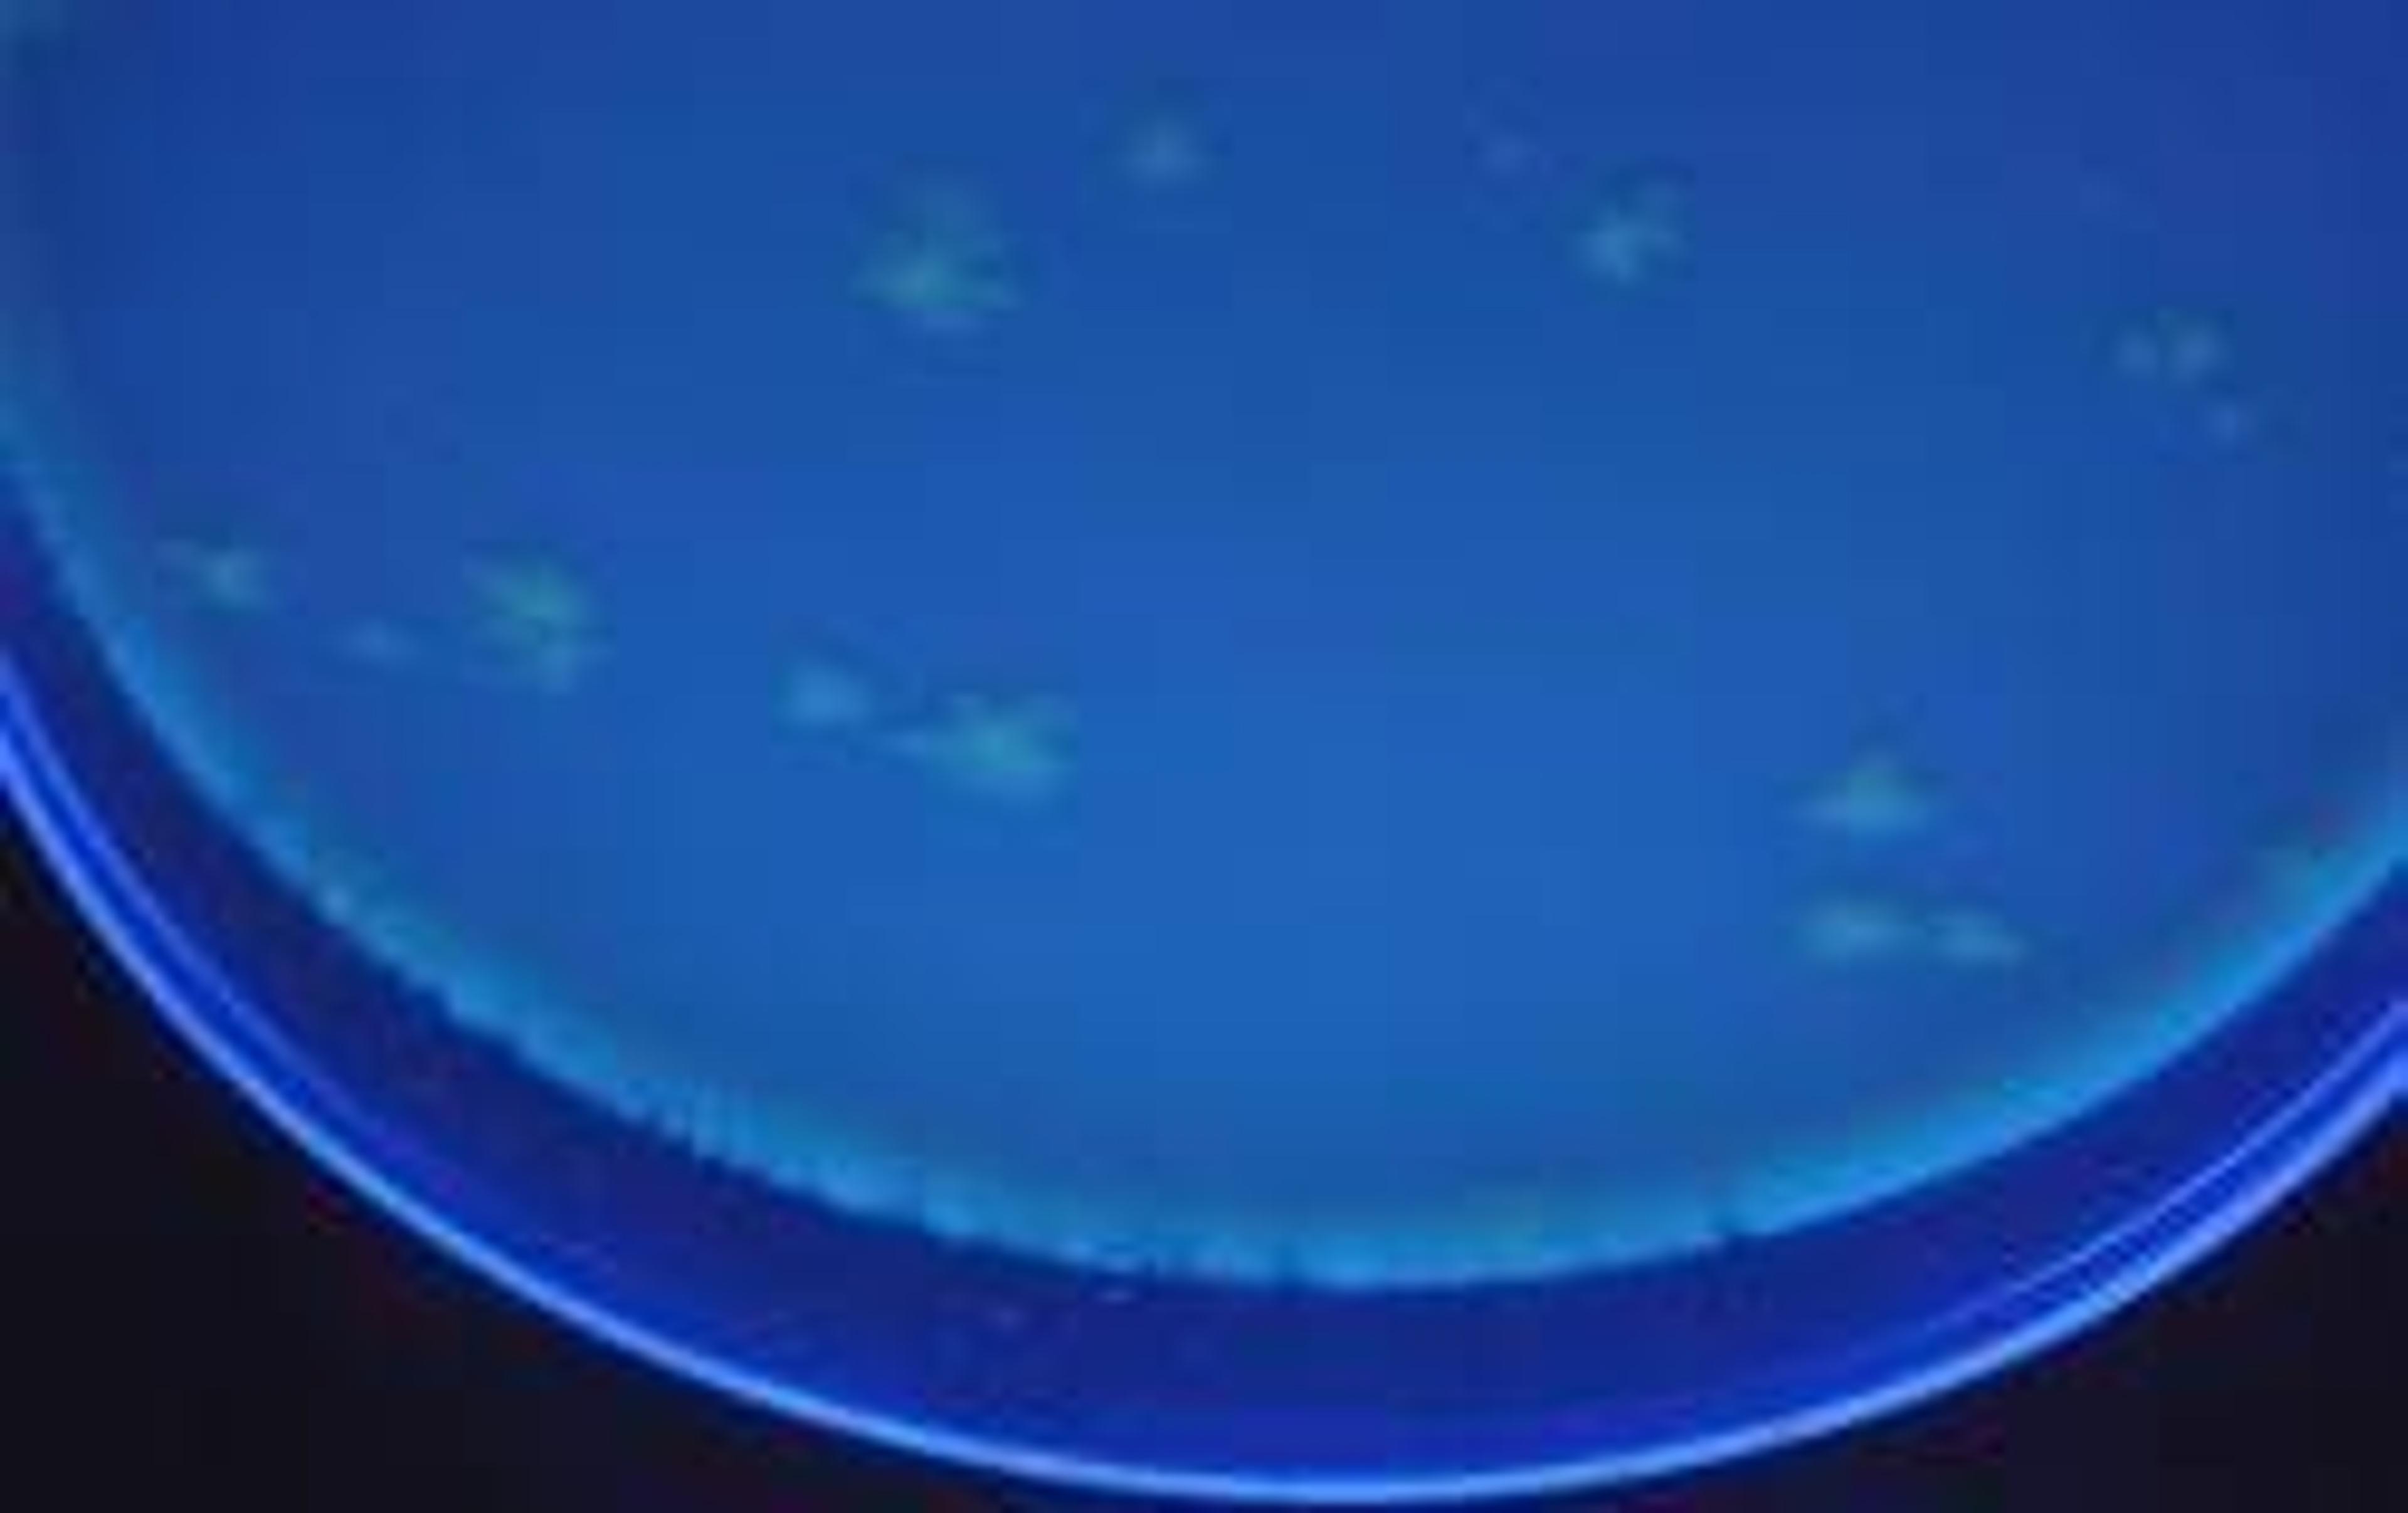

News & Articles
25
Selected Filters:
Product News
Biohit Introduces New Website!
Product News
Affordable microplate solvent evaporator
Product News
High-Sensitivity Automatic Infrared Microscope
Product News
The Only Product Your Laboratory Really Needs
Product News